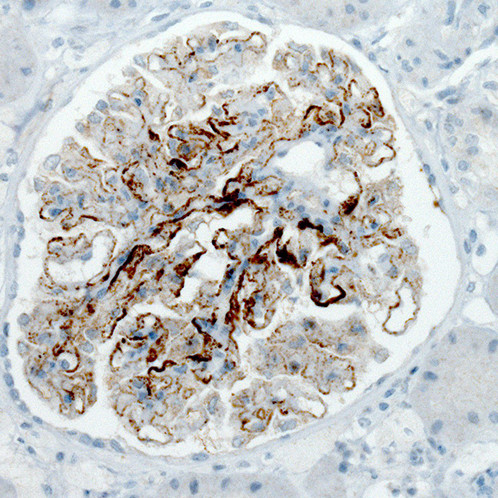
PLA2R1 Antibody in Immunohistochemistry (Paraffin) (IHC (P))

Search
Invitrogen
PLA2R1 Monoclonal Antibody (CL0485)
{{$productOrderCtrl.translations['antibody.pdp.commerceCard.promotion.promotions']}}
{{$productOrderCtrl.translations['antibody.pdp.commerceCard.promotion.viewpromo']}}
{{$productOrderCtrl.translations['antibody.pdp.commerceCard.promotion.promocode']}}: {{promo.promoCode}} {{promo.promoTitle}} {{promo.promoDescription}}. {{$productOrderCtrl.translations['antibody.pdp.commerceCard.promotion.learnmore']}}
产品信息
MA5-24608
种属反应
已发表种属
宿主/亚型
分类
类型
克隆号
偶联物
形式
浓度
规格
纯化类型
保存液
内含物
保存条件
运输条件
RRID
产品详细信息
Immunogen sequence: EEKTWHEALR SCQADNSALI DITSLAEVEF LVTLLGDENA SETWIGLSSN KIPVSFEWSN DSSVIFTNWH TLEPHIFPNR SQLCVSAEQS EGHWKVKNCE ERLFYICKKA GHVLSDAESG CQEGWERHGG FCYKID
Highest antigen sequence identity to the following orthologs: Mouse - 74%, Rat - 76%.
Binds to an epitope located within the peptide sequence VKNCEERLFYICKKA as determined by overlapping synthetic peptides.
靶标信息
Receptor for secretory phospholipase A2 (sPLA2). Acts as a receptor for phosholipase sPLA2-IB/PLA2G1B but not sPLA2-IIA/PLA2G2A. Also able to bind to snake PA2-like toxins. Although its precise function remains unclear, binding of sPLA2 to its receptor participates in both positive and negative regulation of sPLA2 functions as well as clearance of sPLA2. Binding of sPLA2-IB/PLA2G1B induces various effects depending on the cell type, such as activation of the mitogen-activated protein kinase (MAPK) cascade to induce cell proliferation, the production of lipid mediators, selective release of arachidonic acid in bone marrow-derived mast cells. In neutrophils, binding of sPLA2-IB/PLA2G1B can activate p38 MAPK to stimulate elastase release and cell adhesion.
仅用于科研。不用于诊断过程。未经明确授权不得转售。
生物信息学
蛋白别名: 180 kDa secretory phospholipase A2 receptor; C-type lectin domain family 13 member C; M-type receptor; phospholipase A2 receptor 1, 180kD; phospholipase A2 receptor 1, 180kDa; PLA2-R; putative soluble PLA2 receptor precursor; Secretory phospholipase A2 receptor
基因别名: CLEC13C; PLA2-R; PLA2G1R; PLA2IR; PLA2R; PLA2R1
UniProt ID: (Human) Q13018
Entrez Gene ID: (Human) 22925